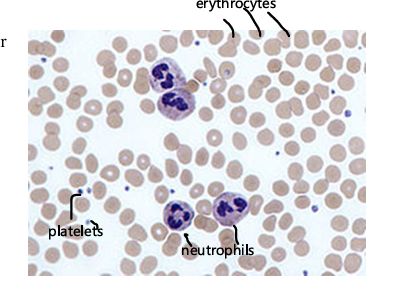
<p>biconcave discs, anucleate, filled with hemoglobin. function: transport oxygen to cells and carbon dioxide away from cells, lifespan of ~120 days, components recycled by liver and spleen after death</p>
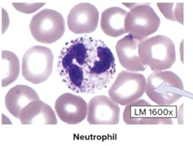
<p>most numerus type of leukocyte, cytoplasm has fine pale granules, nucleus is multilobed (3-5 lobes). functions: phagocytize pathogens, especially bacteria</p>
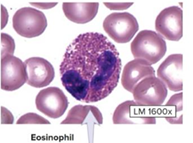
<p>Type of leukocyte, cytoplasm contains prominent granules that stain reddish, nucleus is bilobed, phagocytize allergens, destroys parasitic worms</p>
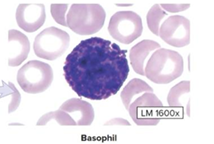
<p>Make up less than 1% of all leukocytes, cytoplasm contains big granules that stain blue/purple, bilobed nucleus, release histamine and heparin during inflammatory or allergic reactions</p>
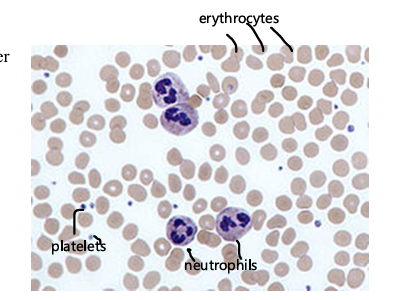
<p>cytoplastic fragments from a larger cell, anucleate, very small, assist with blood clotting</p>

1/180
Looks like no tags are added yet.
Name | Mastery | Learn | Test | Matching | Spaced | Call with Kai |
|---|
No analytics yet
Send a link to your students to track their progress
Plasma
dissolved protein fibers, watery ground substance, 55% component of blood
Formed elements
erythrocytes 44% of blood (red blood cells), leukocytes (white blood cells), platelets (thrombocytes), components of blood
Transportation
oxygen and carbon dioxide, nutrients, waste products, hormones
regulation
temperature, pH, fluid levels
protection
blood clotting, fight against infection (immune response)
buffy coat
platelets and leukocytes, approximately <1% component of blood
erythrocytes
biconcave discs, anucleate, filled with hemoglobin. function: transport oxygen to cells and carbon dioxide away from cells, lifespan of ~120 days, components recycled by liver and spleen after death
leukocytes
larger than erythrocytes, function: generate an immune response, flexible and motile (able to leave blood vessels to travel to body tissues, 5 types - never let monkeys eat bananas

Neutrophils
most numerus type of leukocyte, cytoplasm has fine pale granules, nucleus is multilobed (3-5 lobes). functions: phagocytize pathogens, especially bacteria
lymphocytes
type of leukocyte, cytoplasm lacks visible granules, contains large, round dark purple nucleus, thin ring of pale blue cytoplasm, most located in lymphoid tissues

T-lymphocytes
type of lymphocyte, coordinate immune activity
B-lymphocytes
type of lymphocytes, produce antibodies
Natural killer cells
type of lymphocytes, attack pathogens and abnormal/infected cells
Monocytes
largest leukocyte, cytoplasm lacks visible granules, pale blue cytoplasm, C-shaped nucleus, phagocytize pathogens, cellular debris, dead cells, leaves blood to become macrophages in tissues

Eosinophils
Type of leukocyte, cytoplasm contains prominent granules that stain reddish, nucleus is bilobed, phagocytize allergens, destroys parasitic worms
Basophils
Make up less than 1% of all leukocytes, cytoplasm contains big granules that stain blue/purple, bilobed nucleus, release histamine and heparin during inflammatory or allergic reactions
platelets
cytoplastic fragments from a larger cell, anucleate, very small, assist with blood clotting
apex
point of the heart

base
posterior/left atrium

right atrium
upper right chamber

left atrium
upper left chamber

right ventricle
lower right chamber

left ventricle
lower left chamber

fibrous pericardium
outermost layer, dense connective tissue, prevents heart from overfilling, restricts heart movements

serous pericardium
folds back on itself to create two specific layers

parietal layer
outer layer of serous pericardium, adheres to fibrous pericardium

visceral layer
inner layer of serous pericardium, adheres to heart wall

pericardial cavity
in between the fold of the parietal and visceral layers, contains serous fluid to reduce friction

Endocardium
endothelium covering a CT layer, lines the inside of the heart and covers its valves

Myocardium
cardiac muscle, thickest layer

Epicardium
visceral layer of the serous pericardium, thin serous membrane and fat

cardiac muscle
short, cylindrical cells, some cells are bifurcated (branching), one or two centrally located nuclei, intercalated discs (cell junctions that transmit nerve impulses), striations, involuntary, contracts to pump blood

Superior and inferior vena cava
right atrium receives venous (deoxygenated) blood from these

Right tricuspid valve
blood flows from the right atrium to right ventricle through here

papillary muscles
assists with proper closure of tricuspid valves, in the right and left ventricles

chordae tendineae
form the papillary muscles to the 3 flaps of the right tricuspid valve, prevent the flaps from being everted into the atrium, “heart strings”

pulmonary trunk
blood runs from the right ventricle into here

pulmonary semilunar valve
blood runs through this valve with three semilunar cusps to enter the pulmonary trunk

pulmonary veins
left atrium receives oxygenated blood from the lungs via 3 or 4 of these

left bicuspid valve
blood flows from the left atrium to the left ventricle through this valve

aorta
oxygenated blood from the left ventricle is pumped into here

aortic semilunar valve
oxygenated blood is pumped from the left ventricle to the aorta through this valve

arterial circulation
right coronary artery, left coronary artery, supply the heart cardiac muscle

Coronary sinus
most veins unite/drain into this, and then into the right atrium for venous circulation on the hearts cardiac muscle

autorhythmicity
the heart itself is responsible for initiating the heartbeat, vagus nerve tells how fast or slow for the heart to beat
sinoatrial node (SA)
upper wall of right atrium, responsible for initiating heartbeat

atrioventricular node (AV)
lies in the floor of the right atrium, also initiates the heartbeat

atrioventricular bundle
a bundle of conducting muscle fibers that runs through the interventricular septum

Left and Right bundle branches
AV bundles split to form these, each bundle branch goes to its respective ventricle

subendocardial branches
specialized conduction muscle cells, larger than other cardiac muscle fibers, extend through the walls of the ventricles

Artery
take blood away from the heart and to other tissues, transports blood high in oxygen, thick springy wall, higher blood pressure in arteries than veins

Veins
take back blood to the heart, transport blood low in oxygen and high in carbon dioxide, thinner and collapsible walls, vein lumens are much larger than lumens in arteries, lower blood pressure

capillaries
tiny vessels that connect the smallest arteries and veins, has just a tunica intima, gas/nutrient exchange occurs here

pathway of blood
heart, elastic arteries, muscular arteries, arterioles, capillaries, venules, veins, heart
Tunica Externa
outermost layer, areolar connective tissue, largest layer in veins

Tunica Media
middle layer, circularly arranged smooth muscle fibers, largest layer in arteries, sympathetic innervation casues

tunica intima
innermost layer, endothelium (simple squamous epithelium) and areolar connective tissue

Elastic artery
vessel wall contains large amounts of elastic protein fibers

muscular artery
less elastic than elastic arteries, more smooth muscle in the tunica media

arteriole
tunica media consists of 6 or fewer layers of smooth muscle

venules
collect blood from capillaries, forms veins when they unite

valves
help push blood back to heart, prevent backflow

varicose veins
dilated, tortuous veins, caused by incompetent valves, risk factors include obesity, pregnancy, standing for long periods

skeletal muscle pumps
also help blood be pushed in veins toward heart, contraction of skeletal muscles, ex: gastrocnemius and soleus pump blood from legs to heart
deep vein thrombosis
if inactive, blood and can pool and clot in the veins, happens if blood doesn’t get properly pushed through vessel
ascending aorta
coronary arteries, right and left

aortic arch
after the ascending aorta, has three branches

brachiocephalic trunk
left out of the aortic arch

common carotid
middle out of the aortic arch

subclavian artery
right out of the aortic arch

descending thoracic aorta

descending abdominal aorta

internal iliac artery
branching posteriorly into the pelvis

external iliac artery
branching anteriorly to pass under the inguinal ligament

superior vena cava
L and R brachiocephalic veins

inferior vena cava
veins inferior to diaphragm

external carotid artery
branches supplying the neck and the external skull

internal carotid artery
carries blood directly to the internal skull

superficial temporal artery
continuation in the temporal region from each external carotid artery

vertebral artery
each has ascended through the series of transverse foramen in the cervical vertebrae

external jugular vein
superficial, from the lateral neck and inferior to the face, over the sternocleidomastoid muscle to the subclavian vein

internal jugular vein
deep, running most of its length close to the internal and common carotid arteries, draining to the subclavian vein

cerebral arterial circle
single artery formed by the named arterial sections that connect the basilar and internal carotid arteries beneath the brain

basilar artery
formed where the vertebral arteries join inside the cranial cavity

subclavian artery
the right one being a division of the brachiocephalic trunk, the left one a branch off the aortic arch

axillary artery
each a continuation of that side’s subclavian artery after is passes the first rib

brachial artery
each a continuation of that side’s axillary artery after it has passed the teres major muscle

radial artery
a branch of each brachial artery passing form the cubital fossa along the anterolateral forearm to the wrist

ulnar artery
a branch of each brachial artery passing from the cubital fossa along the anteromedial forearm

superficial palmar arch
a joining of the radial and ulnar arteries in the palm

cephalic vein
superficial veins begin as superficial venous networks which drain into the basilic vein and this vein, may be seen in the arm lateral to the biceps brachii and between the pectoralis major and deltoid, connected with basilic vein by median cubital vein

basilic vein
superficial veins begin as superficial venous networks which drain into the cephalic vein and this vein, this vein and cephalic veins are connected by median cubital vein

median cubital vein
cephalic and basilic veins are connected by this vein on the anterior side of the elbow

internal thoracic artery
passes down the anterior thorax lateral to the sternum

anterior intercostal artery
from each internal thoracic artery, a series of these arteries with one beneath each rib on that side

posterior intercostal artery
on each side, one beneath each rib, these join with anterior intercostal artery laterally and beneath each rib

internal thoracic vein
on each side of the sternum, draining blood from that side’s anterior intercostal veins and into its brachiocephalic vein

anterior intercostal vein
vein of the thorax, a series on each side

azygos vein
draining the right thoracic cavity as well as the hemiazygos and accessory hemiazygos veins

hemiazygos vein
draining the left lower thoracic cavity, the accessory hemiazygos vein drains the upper left thoracic cavity
